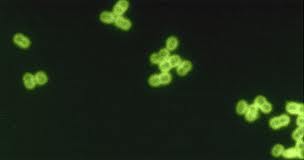
Cientificos Argentinos hallan un mecanismo que explica el incremento de neumococos resistentes a la penicilina

Cientificos Argentinos hallan un mecanismo que explica el incremento de neumococos resistentes a la penicilina
Estas bacterias son responsables de enfermedades como meningitis, neumonía, sinusitis y otitis. Hasta el momento se había demostrado que, sin la administración de antimicrobianos, las cepas resistentes crecían menos que las sensibles. Investigadores de la UNC descubrieron que los neumococos que circulan en Argentina presentan un comportamiento diferente, contraponiéndose a estudios internacionales. Este hallazgo es de interés tanto para infectólogos y epidemiólogos como para la industria farmacéutica.
Los neumococos son bacterias que suelen estar presentes en la nariz y la faringe, particularmente en niños. Pueden originar diferentes infecciones respiratorias como neumonía y meningitis así como desencadenar otitis y sinusitis. Generalmente se tratan con antibióticos llamados beta-lactámicos, entre los cuales la penicilina es el más utilizado.
Cuando el antibiótico es efectivo para tratar las enfermedades producidas por el neumococo se dice que se está ante una cepa sensible a la penicilina. Por el contrario, si el tratamiento no produce resultados, se sostiene que la cepa es resistente a este antimicrobiano. Ambos tipos de neumococos conviven en la nasofaringe, “compitiendo entre sí para establecer una infección en el mismo nicho biológico”.
Estudios internacionales describen que los neumococos sensibles tienen una mayor capacidad de crecimiento que los resistentes mientras no se administran antibióticos. Pero una vez introducido el antimicrobiano, la cepa sensible muere dejando el camino libre a la resistente para originar una infección.
Alertado por el incremento de cepas resistentes en la región central de Argentina en la última década, un equipo de investigadores de la Facultad de Ciencias Químicas de la Universidad Nacional de Córdoba, pertenecientes al Centro de Investigaciones en Bioquímica Clínica e Inmunología (Cibici) y dirigidos por José Echenique, estudió cepas neumocócicas resistentes a penicilina que circulan en Argentina.
Previamente este grupo de científicos había realizado un estudio epidemiológico utilizando 200 cepas patógenas de neumococo. Este trabajo fue realizado en el marco de un programa de epidemiología en el que participaron hospitales pediátricos de Córdoba y otras provincias, estudio que incluyó a niños menores de cinco años.
Como se mencionó previamente, las infecciones causadas por neumococos se tratan generalmente con penicilina u otros antibióticos de la familia de los beta-lactámicos. Para atacar la infección la penicilina debe unirse a unas proteínas involucradas en la división celular de los neumococos, denominadas PBP (Penicilin-Binding Proteins por sus siglas en inglés).
Para que esta unión sea efectiva, es crucial lo que ocurra durante el crecimiento bacteriano. En ese proceso se pueden producir errores o mutaciones en la duplicación del ADN. Si esas mutaciones se producen en el punto justo en el que actúa la penicilina, es decir, en los genes asociados a las PBPs a las que se une la penicilina, la bacteria se vuelve resistente. De este modo, el antibiótico deja de ser efectivo para matar la bacteria.
“Simulamos el proceso evolutivo de las bacterias mediante la incorporación progresiva de mutaciones que aportan resistencia a la penicilina. Lo hicimos con técnicas microbiológicas y luego analizamos las muestras con métodos de biología molecular y celular”.
Para comprender mejor el comportamiento de las cepas resistentes, los investigadores tomaron cepas sensibles y le incorporaron genes (ADN) asociados a PBPs provenientes de cepas resistentes, pero en lugar de introducir los tres genes juntos lo hicieron de a uno para ver cómo era el comportamiento individual de cada mutación en cuanto a crecimiento y resistencia.
Los científicos descubrieron que individualmente cada gen mutante crecía menos que si estaban todos juntos. Esto significaba que la bacteria acumulaba, evolutivamente, aquellas mutaciones que se complementaban entre sí para compensar la capacidad de crecimiento, y que a la vez le aportaban resistencia. Con estudios complementarios comprobaron que en ausencia de antibióticos ambas cepas (sensibles y resistentes) crecían a iguales niveles.
Estos resultados contradecían lo descrito en estudios similares desarrollados por especialistas de Estados Unidos y Europa, según los cuales, en ausencia de antibióticos las cepas resistentes crecían menos que las susceptibles a la penicilina. Entonces realizaron nuevos experimentos en los que compararon los genes de las cepas resistentes que circulan en esos países con los que tenemos en Argentina, para justificar científicamente la diferencia de resultados.
“Tomamos cada gen, lo secuenciamos y los comparamos con los de esos lugares y todas las diferencias fueron evidentes. Las cepas son resistentes sin importar el nivel de resistencia, pero las mutaciones no son ni parecidas”, indica Echenique. “Las cepas de neumococo circulantes en Argentina poseen un mecanismo que facilita la diseminación de las cepas resistentes a la penicilina”, concluye.
Fuente: UNC
Leer mas:
http://www.tomamateyavivate.com.ar/inventos-y-descubrimientos-argentinos/cientificos-argentinos-hallan-un-mecanismo-que-explica-el-incremento-de-neumococos-resistentes-a-la-penicilina/
Por tomamateyavivate
Por tomamateyavivate